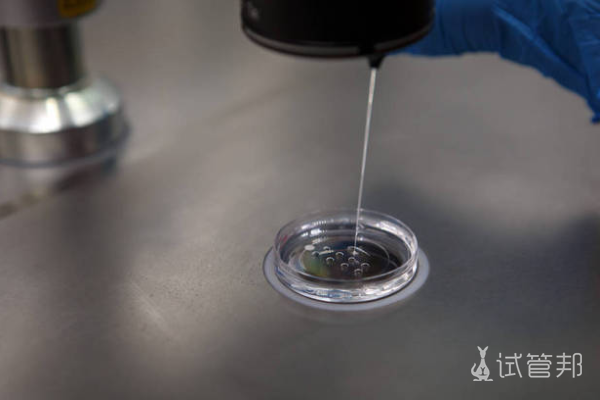
3f209e6decca0a0d86bb45617d41c8ea.png 天津人工授精要多少钱

随着时代的发展,科技的进步,人类正在解决各种各样的问题。这也包括不孕不育的问题。相信很多不孕患者都会想要了解人工授精的费用。那么,天津人工授精要多少钱,包含哪些费用呢?
一般情况下,在天津正规医院做一次人工授精大概需要1-2万元左右。包含以下费用:
1.检查费用大概在5000-6000元:包括男方精子染色体的检查,女方生殖器官的检查。
2.供精费用:天津本地没有精子库,所以往后进行供精人工授精技术,要么在自建精子库的情况下进行;要么需要周边城市运送,后面这一情况所涉及的费用会比较贵。
3.精液优化费用500-1500元左右:精液解冻后需要优化,不活跃的精子会被去除。
4.人工授精的费用大概在1000-2000元:将优化后的精液送入女性宫腔。
5.其他费用1000-10000元左右:部分排卵异常或卵巢功能差的患者需要使用促排卵药物,部分其他疾病患者也需要先进行治疗,再做人工授精。
如果患者卵巢功能差,还可能涉及促排卵费用。具体费用要看药物的用量和药物品牌的选择,然后部分患者有影响人工授精成功率的疾病。就需要在人工授精前进行治疗,费用也会增加。截至目前,天津本地共有12家医院开展了辅助生殖技术。目前这些医院只开展了夫精人工授精,尚未开展供精人工授精。不过,该市也正在积极准备精子库,相信在不久的将来,当地的一些医院会开展这项技术。

另外,做人工授精的患者也要注意年龄因素。如果她们年龄太大,超过了最佳生育年龄,必然会影响人工授精的成功率,从而影响受孕。
总的来说,天津正规医院的人工授精费用不是很贵,大部分家庭都能接受。但是人工授精的成功率并不是很高,只有25%左右。大部分患者需要进行2-3次人工授精才能成功怀孕,费用自然会增加。
